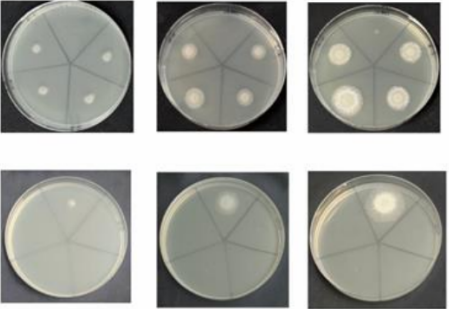

(生物与制药系 姚波)近日,第八届全国大学生生命科学竞赛(科学探究类)赛场传来喜讯,由我院聂菊秋、朱静、陈婷婷三位同学组成的重庆科技学院生命科创队在李勇昊、姚波两位老师指导下荣获重庆市一等奖和全国二等奖。


本次决赛于8月18日分别在西华大学、东北农业大学和南京师范大学举行,共有来自全国562所高校12069支队伍参赛。
全国大学生生命科学竞赛于2017年启动,2021年入选“2020全国普通高校大学生竞赛排行榜”,是教育部认可的57项全国大学生学科竞赛之一,是涵盖生物、食品、医学等高校生命科学领域的顶级权威赛事。该竞赛围绕生命科学相关领域的科学问题,鼓励跨学科领域,开展自主性设计实验或野外调查工作,寻找解决生命科学问题的有效方法。旨在培养大学生的社会责任感、创新意识、团队精神和实践能力,掌握与生命科学领域有关的调查、监测检验、检疫、诊断、分析、预防和控制的基本实验技术与方法。

一直以来,化学化工学院坚持“重应用、强能力、高素质”的培养方式,通过学科竞赛不断激发学生学习热情,加深专业认识,增强专业自信,增强学生专业素养和实践创新能力,培养高素质应用型人才。